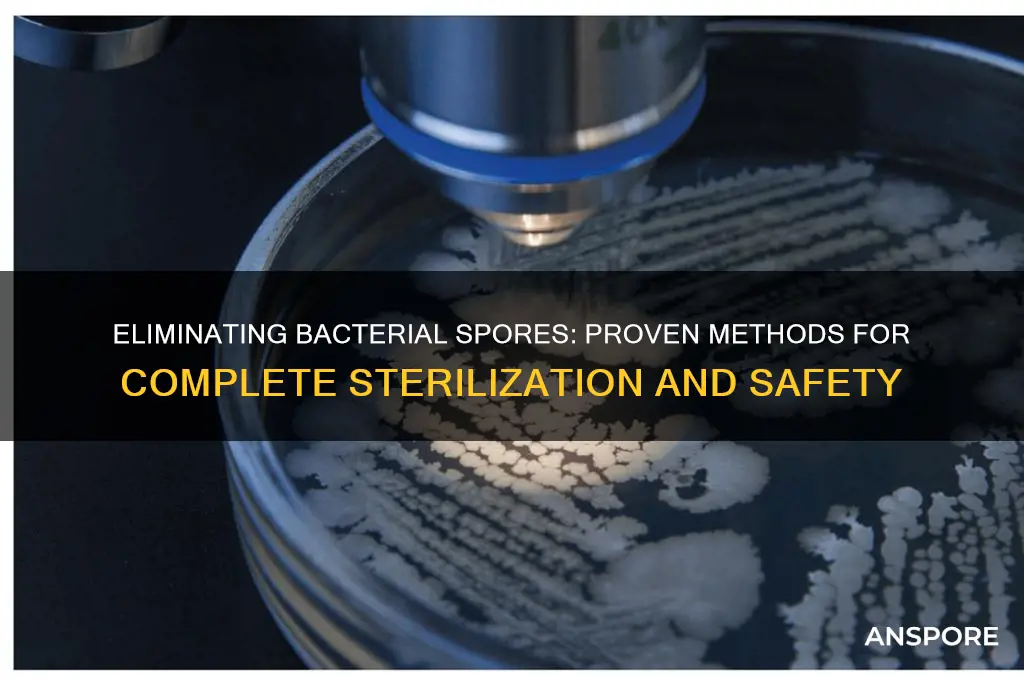
how to ensure no bacteria is in with spores

Ensuring the complete absence of bacteria alongside spores is a critical challenge in various industries, including food safety, pharmaceuticals, and healthcare. Spores, such as those from *Bacillus* and *Clostridium* species, are highly resistant to conventional sterilization methods due to their robust protective coatings. To effectively eliminate both bacteria and spores, a multi-faceted approach is necessary. This typically involves a combination of physical methods like autoclaving, which uses high-pressure steam to denature proteins and disrupt cell membranes, and chemical treatments, such as hydrogen peroxide or peracetic acid, which target cellular structures. Additionally, rigorous validation protocols, including biological indicators and spore-specific assays, are essential to confirm the efficacy of the sterilization process. Proper environmental controls, such as maintaining cleanroom conditions and minimizing contamination risks, further enhance the reliability of these methods. By integrating these strategies, it is possible to achieve a high degree of confidence in the elimination of both bacteria and spores, ensuring safety and compliance in critical applications.
Explore related products
What You'll Learn
- Sterilization Techniques: Autoclaving, dry heat, and chemical methods effectively kill spores and bacteria
- Sporicidal Agents: Use hydrogen peroxide, peracetic acid, or bleach to target spores
- Validation Methods: Employ spore tests and biological indicators to confirm sterilization success
- Cleanroom Protocols: Maintain sterile environments with HEPA filters and controlled access
- Spores Detection: Use PCR, microscopy, or culture tests to identify spore presence

Sterilization Techniques: Autoclaving, dry heat, and chemical methods effectively kill spores and bacteria
Spores, the resilient survival forms of certain bacteria, pose a unique challenge in sterilization due to their ability to withstand extreme conditions. Traditional cleaning methods often fall short, leaving these dormant threats lurking. To ensure complete eradication, we turn to specialized techniques: autoclaving, dry heat, and chemical sterilization.
Each method leverages a distinct mechanism to dismantle the spore's defenses.
Autoclaving: The Power of Steam
Autoclaving reigns supreme in many laboratory and medical settings. This method utilizes saturated steam under pressure, typically at 121°C (250°F) for 15-30 minutes, to penetrate even the most stubborn spores. The intense heat and pressure denature proteins, disrupt cell membranes, and ultimately destroy the spore's genetic material. For optimal results, ensure proper loading of the autoclave, allowing for adequate steam penetration, and use appropriate sterilization indicators to confirm the process's effectiveness.
Regular maintenance and calibration of the autoclave are crucial to guarantee consistent performance.
Dry Heat: A Slow Burn for Stubborn Spores
Dry heat sterilization, while slower than autoclaving, offers a viable alternative for heat-resistant materials. This method employs temperatures of 160-170°C (320-340°F) for 2-3 hours. The absence of moisture necessitates longer exposure times, as heat transfer is less efficient. However, dry heat effectively destroys spores by oxidizing cellular components and damaging DNA. This method is particularly useful for sterilizing powders, oils, and other substances that may be damaged by moisture.
Caution must be exercised when using dry heat, as prolonged exposure can degrade certain materials.
Chemical Sterilization: A Targeted Approach
Chemical sterilants provide a valuable option for heat-sensitive materials or situations where autoclaving or dry heat are impractical. Ethylene oxide gas, for instance, penetrates materials effectively, disrupting spore metabolism and DNA replication. However, its use requires specialized equipment and strict safety protocols due to its toxicity. Liquid sterilants like glutaraldehyde offer another option, but require longer contact times and careful disposal.
Choosing the Right Method:
The choice of sterilization technique depends on the material to be sterilized, the desired turnaround time, and safety considerations. Autoclaving remains the gold standard for heat-resistant materials, while dry heat offers a suitable alternative for moisture-sensitive items. Chemical methods provide a targeted solution for specific applications, but require careful handling and disposal. By understanding the strengths and limitations of each technique, we can effectively eliminate both bacteria and their resilient spore forms, ensuring a truly sterile environment.
Understanding Spores: Do They Belong to the Sporophyte Generation?
You may want to see also

Sporicidal Agents: Use hydrogen peroxide, peracetic acid, or bleach to target spores
Spores, with their resilient nature, pose a unique challenge in disinfection. Unlike vegetative bacteria, they require specialized agents to ensure complete eradication. Here, we delve into the efficacy of sporicidal agents like hydrogen peroxide, peracetic acid, and bleach, offering a practical guide to their application.
Hydrogen Peroxide: A Versatile Oxidizer
Hydrogen peroxide, a readily available and relatively inexpensive solution, stands out for its broad-spectrum antimicrobial activity. Its sporicidal efficacy is attributed to its ability to generate hydroxyl radicals, which damage cellular components, including DNA and proteins. For effective spore inactivation, concentrations of 6-30% are recommended, with contact times ranging from 10 minutes to several hours depending on the spore type and desired log reduction. Vaporized hydrogen peroxide, a newer application method, offers advantages in hard-to-reach areas and enclosed spaces.
Peracetic Acid: Potent but Precise
Peracetic acid, a powerful oxidizing agent, exhibits rapid sporicidal activity even at low temperatures. Its effectiveness stems from its ability to penetrate spore coats and disrupt cellular metabolism. Typically used at concentrations of 0.2-0.5%, peracetic acid requires shorter contact times compared to hydrogen peroxide, often achieving complete spore inactivation within minutes. However, its corrosive nature necessitates careful handling and material compatibility considerations.
Bleach: A Household Staple with Limitations
Household bleach, a sodium hypochlorite solution, is a widely recognized disinfectant. While effective against many bacteria, its sporicidal activity is limited. High concentrations (5-10%) and prolonged contact times (up to 24 hours) are necessary for spore inactivation, making it less practical for certain applications. Additionally, bleach's corrosive nature and potential for generating harmful byproducts limit its use in specific settings.
Choosing the Right Agent: A Balancing Act
The selection of a sporicidal agent depends on various factors, including the type of spores present, the surface or material to be treated, and safety considerations. Hydrogen peroxide offers versatility and effectiveness, while peracetic acid provides rapid action but requires careful handling. Bleach, though readily available, has limitations in spore inactivation and safety. Understanding the strengths and weaknesses of each agent is crucial for ensuring successful spore eradication in diverse settings.
Spore Syringe Shelf Life: Room Temperature Storage Duration Explained
You may want to see also

Validation Methods: Employ spore tests and biological indicators to confirm sterilization success
Spore tests and biological indicators are the gold standard for validating sterilization processes, providing empirical evidence that no viable microorganisms, including bacterial spores, remain. These methods rely on the principle of challenging the sterilization process with highly resistant spores, typically from *Geobacillus stearothermophilus* or *Bacillus atrophaeus*. If these spores are inactivated, it confirms the process’s efficacy against less resilient bacteria. This approach is critical in industries like healthcare, pharmaceuticals, and food production, where sterility is non-negotiable.
To implement spore testing, follow these steps: First, place biological indicators (BIs) containing spore strips in the sterilization chamber, ensuring they are positioned in the most challenging locations, such as the center of a load or near the door. Second, run the sterilization cycle as usual. Third, incubate the BIs in growth media at the manufacturer’s specified temperature (e.g., 55–60°C for *G. stearothermophilus*) for the recommended duration, typically 24–48 hours. If no growth occurs, the cycle is validated. Any visible turbidity or color change indicates spore survival, necessitating process review and revalidation.
A comparative analysis highlights the superiority of spore tests over chemical indicators or temperature monitoring alone. While chemical indicators confirm exposure to sterilization conditions, they do not verify microbial kill. Similarly, temperature logs ensure the cycle reached target levels but cannot account for variables like load distribution or equipment malfunction. Spore tests, however, provide definitive proof of lethality, making them indispensable for critical applications. For instance, in autoclaving, a failed spore test may reveal issues like insufficient steam penetration or inadequate cycle timing.
Practical tips for maximizing the reliability of spore tests include using certified BIs from reputable manufacturers, rotating test locations to account for chamber variability, and maintaining meticulous records of test results. Additionally, ensure staff are trained in proper placement and interpretation of BIs. For example, in dental clinics, weekly spore tests are recommended to comply with CDC guidelines, while pharmaceutical facilities may require daily testing due to higher sterility demands.
In conclusion, spore tests and biological indicators are not just regulatory requirements but essential tools for ensuring sterilization success. Their ability to detect even the hardiest microorganisms provides a level of assurance that no other method can match. By integrating these validation methods into routine protocols, organizations can safeguard against contamination, protect public health, and maintain operational integrity.
Exploring Plant Spores: Dispersal Methods and Survival Strategies in Nature
You may want to see also
Explore related products

Cleanroom Protocols: Maintain sterile environments with HEPA filters and controlled access
In critical environments where even the slightest contamination can compromise results, cleanroom protocols serve as the backbone of sterility. At the heart of these protocols lies the High-Efficiency Particulate Air (HEPA) filter, a device capable of trapping 99.97% of particles as small as 0.3 microns. This includes bacterial spores, which are notoriously resilient and can survive extreme conditions. HEPA filters are not just installed; they are strategically placed in HVAC systems to create positive air pressure, ensuring that air flows from clean to less clean areas, thereby preventing contamination ingress. Regular testing and certification of these filters, using methods like the DOP (Dioctyl Phthalate) test, are mandatory to verify their efficiency. Without such vigilance, spores could bypass filtration, rendering the cleanroom compromised.
Controlled access is the second pillar of cleanroom sterility, acting as a human-centric barrier to contamination. Personnel must adhere to strict gowning procedures, donning sterile garments, gloves, and sometimes even full-body suits to minimize particulate shedding. Air showers, equipped with high-velocity jets, are positioned at entry points to dislodge particles from clothing before entry. Access is further restricted by limiting the number of occupants and requiring training in aseptic techniques. For instance, in pharmaceutical cleanrooms, employees often undergo "touch training" to learn how to handle materials without introducing contaminants. Even the timing of access matters: high-risk procedures are scheduled during periods of minimal foot traffic to reduce spore introduction.
The interplay between HEPA filtration and controlled access creates a synergistic effect, but it’s not foolproof. Spores, due to their small size and aerodynamic nature, can still pose a threat if protocols are not meticulously followed. For example, a single sneeze in a cleanroom can generate droplets containing spores, which, if not captured by HEPA filters, could settle on surfaces. To mitigate this, cleanrooms often employ additional measures like laminar flow cabinets, which provide localized ultra-clean air for critical tasks. Furthermore, routine environmental monitoring—using settle plates and air samplers—is essential to detect spore presence before it escalates into a full-blown contamination event.
A comparative analysis of cleanroom classifications (e.g., ISO Class 5 vs. ISO Class 8) reveals that stricter standards demand more rigorous protocols. In an ISO Class 5 cleanroom, used for tasks like semiconductor manufacturing or sterile drug compounding, air changes occur 240–600 times per hour, and personnel are limited to 1–2 individuals. In contrast, an ISO Class 8 cleanroom, suitable for less critical applications, may only require 20–40 air changes per hour. This highlights the scalability of cleanroom protocols based on the risk of spore contamination. Industries must therefore tailor their protocols to their specific needs, balancing sterility requirements with operational feasibility.
Ultimately, maintaining a spore-free environment in cleanrooms is a multidisciplinary endeavor, blending engineering, microbiology, and human behavior. HEPA filters and controlled access are not standalone solutions but components of a holistic system. Success hinges on continuous training, stringent monitoring, and a culture of accountability. For instance, a cleanroom operator in the biotech industry once noted, "The cleanroom doesn’t fail; people fail the cleanroom." This underscores the importance of treating protocols not as checklists but as living practices that evolve with technology and threat landscapes. By doing so, industries can safeguard their processes against the invisible yet persistent threat of bacterial spores.
Can C. Diff Spores Survive on Your Clothes? Find Out Here
You may want to see also

Spores Detection: Use PCR, microscopy, or culture tests to identify spore presence
Detecting spores amidst bacterial contamination requires precision. Three primary methods—PCR, microscopy, and culture tests—offer distinct advantages and limitations. PCR (Polymerase Chain Reaction) amplifies specific DNA sequences, enabling highly sensitive detection of spore-forming bacteria like *Bacillus* or *Clostridium*. This method is ideal for identifying low-concentration spores but requires prior knowledge of the target organism’s genetic markers. For instance, using primers targeting the *16S rRNA* gene can broadly detect spore-forming bacteria, while species-specific primers provide precise identification. PCR’s rapid turnaround (2–4 hours) makes it suitable for time-sensitive applications, such as pharmaceutical or food safety testing.
Microscopy, in contrast, provides a visual approach. Spores can be stained with dyes like malachite green or heat-fixed to enhance visibility under a light or fluorescence microscope. This method is cost-effective and does not require specialized equipment, making it accessible for field or resource-limited settings. However, microscopy lacks specificity, as spores can resemble other cellular debris or non-viable particles. For accurate results, combine microscopy with additional tests, such as spore germination assays, to confirm viability. A practical tip: use phase-contrast microscopy to enhance spore detection without staining, reducing preparation time.
Culture tests remain the gold standard for spore viability assessment. Spores are cultured in nutrient-rich media, such as tryptic soy agar, under optimal conditions (e.g., 37°C for 24–48 hours). If colonies form, spores are confirmed as viable. This method is straightforward but time-consuming and may underestimate spore counts if they are in a dormant state. To improve accuracy, perform a heat shock (80°C for 10 minutes) before culturing to eliminate vegetative bacteria and activate spores. Culture tests are particularly useful in industries like water treatment, where ensuring spore-free environments is critical.
Choosing the right method depends on the context. For rapid, high-specificity detection, PCR is unparalleled. Microscopy offers a quick visual assessment but requires complementary techniques for confirmation. Culture tests provide definitive viability data but demand patience. Combining these methods—for example, using PCR for initial screening and culture tests for validation—ensures robust spore detection. Always consider the sample matrix (e.g., soil, food, or clinical specimens) and adjust protocols accordingly, such as using DNA extraction kits optimized for spore-rich samples in PCR. By leveraging these tools strategically, you can confidently ensure no bacteria masquerade as spores in your analysis.
Unseen Airborne Spores: How Do They Dominate Our Atmosphere?
You may want to see also
Frequently asked questions
To ensure no bacteria are present with spores, use a combination of heat treatment (e.g., 80°C for 10 minutes) to kill vegetative bacteria and follow with spore-specific sterilization methods like autoclaving (121°C, 15-30 minutes) or chemical sterilants (e.g., hydrogen peroxide or peracetic acid).
Yes, filtration using a 0.22 μm filter can effectively remove most bacteria while allowing smaller spores to pass through. However, this method does not kill spores, so additional sterilization steps may be necessary.
Heat-sensitive detergents or antibiotics (e.g., lysozyme or penicillin) can target and kill vegetative bacteria while leaving spores intact. Follow with spore-specific treatments for complete sterilization.
Perform a bacterial viability test (e.g., plate counting or PCR) to confirm the absence of bacteria. For spores, use a spore-specific assay like the spore germination test or microscopy after staining with malachite green to ensure they are still present.































